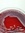
Grace C...

“It is quite possible--overwhelmingly probable, one might guess--that we will always learn more about human life and personality from novels than from scientific psychology”
―
―
“She always says she dislikes the abnormal, it is so obvious. She says the normal is so much more simply complicated and interesting.”
― The Autobiography of Alice B. Toklas
― The Autobiography of Alice B. Toklas
Melissa’s 2025 Year in Books
Take a look at Melissa’s Year in Books, including some fun facts about their reading.
More friends…
Favorite Genres
Polls voted on by Melissa
Lists liked by Melissa